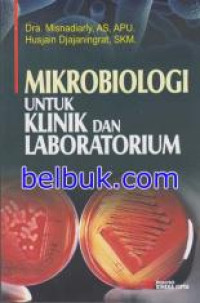

Detail Cantuman
Advanced Search
BUKU TEXT KOLEKSI PERPUS
Mikrobiologi untuk klinik dan laboratorium
Tidak Tersedia Deskripsi
Ketersediaan
B000725Q1 | 616.01 MIS m | RAK KOLEKSI BUKU (4-A.5) | Tersedia |
B000725Q2 | 616.01 MIS m | RAK KOLEKSI BUKU (4-B.5) | Tersedia |
B000725Q3 | 616.01 MIS m | RAK KOLEKSI BUKU (4-B.5) | Tersedia |
B000725Q4 | 616.01 MIS m | RAK KOLEKSI BUKU (4-D.5) | Tersedia |
B000725Q5 | 616.01 MIS m | RAK KOLEKSI BUKU (4-B.5) | Tersedia |
Informasi Detil
Judul Seri |
-
|
---|---|
No. Panggil |
616.01 MIS m
|
Penerbit | Rineka Cipta : Jakarta., 2014 |
Deskripsi Fisik |
ix, 227 hlm. ; 24 cm
|
Bahasa |
Indonesia
|
ISBN/ISSN |
978-979-098-062-4
|
Klasifikasi |
616.01 MIS m
|
Tipe Isi |
-
|
Tipe Media |
-
|
---|---|
Tipe Pembawa |
-
|
Edisi |
-
|
Subyek | |
Info Detil Spesifik |
-
|
Pernyataan Tanggungjawab |
-
|
Versi lain/terkait
Judul | Edisi | Bahasa |
---|---|---|
Food Mycology - A Multifaceted approach to fungi and food - Mikologi Makanan | en | |
Mikologi : Dasar dan terapan | id |